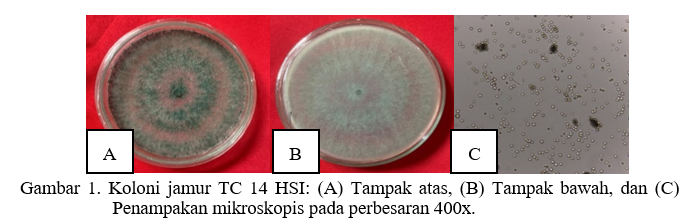

Jurnal Proteksi Agrikultura (JPA) publishes research articles related to plant pests, plant pathogens, and the management of plant damage caused by these pests and pathogens in tropical and subtropical regions. In addition to original research papers, JPA also features short communications and unpublished reviews. Manuscripts submitted for publication undergo rigorous peer review. The journal is published biannually in May and November by the Plant Protection Department at the Faculty of Agriculture, Universitas Lampung, Indonesia, in collaboration with the Entomological Society of Indonesia and the Indonesian Phytopathological Society.
Articles
Eksplorasi dan uji patogenisitas jamur entomopatogen di PTPN VII Unit Bunga Mayang sebagai pengendali hayati hama penggerek batang tebu (Chilo sacchariphagus)
1-9 Pages
Pengaruh konsentrasi bakteri entomopatogen Bacillus thuringiensis terhadap mortalitas larva kumbang tanduk (Oryctes rhinoceros) secara in vitro
10-14 Pages
Uji Efektivitas Trichoderma asperellum dalam Pengendalian Nematoda Puru Akar (Meloidogyne spp.) Secara In Vitro
15-20 Pages
Pengaruh implementasi Netamax-FP Unila terhadap keragaman dan kelimpahan nematoda dalam tanah pada pertanaman guava kristal di Lampung
21-30 Pages
Deteksi dan Identifikasi Mikroorganisme Terbawa Benih Cabai Rawit (Capsicum frutescens L.) yang dijual pada Marketplace
31-40 Pages